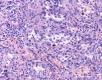
Figure 4 .Anastomosing channels lined by tall and plump cells, showing micropapillary architecture in some regions, but without nuclear atypia or mitotic activity. Deposition of hemosiderin can be seen in some cells. ( Courtesy  Dr . V . Penopoulos ) .
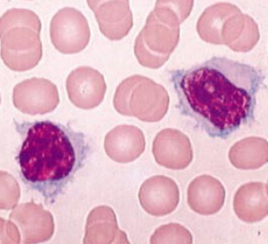
CD79a positivity (Courtesy Dr. V. Penopoulos)

Lower Abdomen
Κάτω Κοιλία
312 images · 4 sub-chapters

Liver after resection of the infected cyst. Presence of hemostatic Surgicel on the raw surface (Courtesy Dr. V. Penopoulos)

Polycystic liver disease. Red arrow. Infected hepatic cyst (Courtesy Dr. V. Penopoulos)

Spindle-shaped cells organized in fascicles, with hyperchromatic nuclei (Courtesy Dr. V. Penopoulos)

Spindle-shaped cells organized in fascicles, with hyperchromatic nuclei (Courtesy Dr. V. Penopoulos)

CT Angiography. Presence of a ruptured pseudoaneurysm of the common hepatic artery (Courtesy Dr. V. Penopoulos)

Abdominal computed tomography. Cystic lesion of the right lung. Courtesy Dr. V. Penopoulos.

Red arrows — Anterior and posterior cystic arteries. Green arrow — Cystic duct (Courtesy Dr. V. Penopoulos)

Red arrows — Anterior and posterior cystic arteries. Green arrow — Cystic duct (Courtesy Dr. V. Penopoulos)

Red arrows — Anterior and posterior cystic arteries. Green arrow — Cystic duct (Courtesy Dr. V. Penopoulos)

Hepatic abscess in a patient with cholecystocolic fistula and gallbladder empyema (Courtesy Dr. V. Penopoulos)

Multiple hepatic abscesses in other patients with cholecystocolic fistulas (Courtesy Dr. V. Penopoulos)

Multiple hepatic abscesses in other patients with cholecystocolic fistulas (Courtesy Dr. V. Penopoulos)

Hepatic abscess in a patient with cholecystocolic fistula and gallbladder empyema (Courtesy Dr. V. Penopoulos)

Hepatic abscess in a patient with cholecystocolic fistula and gallbladder empyema (Courtesy Dr. V. Penopoulos)

Red arrow — Inflammatory reaction between the hepatic flexure and gallbladder. Green arrow — Gallbladder. Yellow arrow — Right colon (Courtesy Dr. V. Penopoulos)

Hepatic abscess in a patient with cholecystocolic fistula and gallbladder empyema (Courtesy Dr. V. Penopoulos)

Peritoneovenous shunt in another patient with decompensated hepatic cirrhosis (Courtesy Dr. V. Penopoulos)

Peritoneovenous shunt in another patient with decompensated hepatic cirrhosis (Courtesy Dr. V. Penopoulos)

Peritoneovenous shunt in another patient with decompensated hepatic cirrhosis (Courtesy Dr. V. Penopoulos)

Peritoneovenous shunt in another patient with decompensated hepatic cirrhosis (Courtesy Dr. V. Penopoulos)

Peritoneovenous shunt in another patient with decompensated hepatic cirrhosis (Courtesy Dr. V. Penopoulos)

Total Hysterectomy specimen .Both ovaries occupied by the signet cell gallbladder carcinoma (Courtesy Dr. V. Penopoulos)

Total Hysterectomy specimen .Both ovaries occupied by the signet cell gallbladder carcinoma (Courtesy Dr. V. Penopoulos)

Total Hysterectomy specimen .Both ovaries occupied by the signet cell gallbladder carcinoma (Courtesy Dr. V. Penopoulos)

Total Hysterectomy specimen .Both ovaries occupied by the signet cell gallbladder carcinoma (Courtesy Dr. V. Penopoulos)

Total Hysterectomy specimen .Both ovaries occupied by the signet cell gallbladder carcinoma (Courtesy Dr. V. Penopoulos)

Total Hysterectomy specimen .Both ovaries occupied by the signet cell gallbladder carcinoma (Courtesy Dr. V. Penopoulos)

Total Hysterectomy specimen .Both ovaries occupied by the signet cell gallbladder carcinoma (Courtesy Dr. V. Penopoulos)

Yellow arrow — Contrast collection in the gallbladder fossa. Red arrow — Injured Luschka duct (Courtesy Dr. V. Penopoulos)

Patient CT, 6th postoperative day. Contrast in the gallbladder fossa. Red arrow — Injured Luschka duct (Courtesy Dr. V. Penopoulos)

Patient CT, 6th postoperative day. Contrast in the gallbladder fossa. Red arrow — Injured Luschka duct (Courtesy Dr. V. Penopoulos)

Multiple liver abscesses, 6 months and 1 year following pancreaticoduodenectomy (Courtesy Dr. V. Penopoulos)

The continuation of the AAA sac below the level of the ligament of Treitz (Courtesy Dr. V. Penopoulos)

The preoperative placement of a plastic stent in the common bile duct is visible (Courtesy Dr. V. Penopoulos)

After completion of the pancreatic head resection, the following are demonstrated: (brown arrow) the AAA sac, (blue arrow) the confluence of the superior mesenteric vein with the splenic vein and the formation of the portal vein, and (green arrow) the body of the pancreas (Courtesy Dr. V. Penopoulos)

Blue arrow – The body of the pancreas, fully mobilized, ready for the pancreaticogastric anastomosis, and Green arrow – Jejunal loop, ready for the gastrojejunal anastomosis (Courtesy Dr. V. Penopoulos)

Completion of the pancreaticogastric anastomosis – Green arrow – demonstrates the pancreas secured within the gastric lumen (Courtesy Dr. V. Penopoulos)

Preparation of vascular branches and excision of mesopancreas (Courtesy Dr. V. Penopoulos)

.Urine microscopy showing the presence of muddy brown granular casts with bile staining (Courtesy Dr. V. Penopoulos)

.Urine microscopy showing the presence of muddy brown granular casts with bile staining (Courtesy Dr. V. Penopoulos)

Specimen ( pancreatic head ) following modified Whipple’s operation (Courtesy Dr. V. Penopoulos)

Specimen ( pancreatic head ) following modified Whipple’s operation (Courtesy Dr. V. Penopoulos)

Preparation of vascular branches and excision of mesopancreas (Courtesy Dr. V. Penopoulos)

MRCP image confirms the absence of gallbladder and a normal biliary tree (Courtesy Dr. V. Penopoulos)

MRCP image confirms the absence of gallbladder and a normal biliary tree (Courtesy Dr. V. Penopoulos)

MRCP image confirms the absence of gallbladder and a normal biliary tree (Courtesy Dr. V. Penopoulos)

Compression of the common hepatic duct by the right hepatic artery is evident. Red arrows: right and left hepatic artery. Blue arrow: proper hepatic artery. Brown arrow: common hepatic artery. Purple arrow: gastroduodenal artery (Courtesy Dr. V. Penopoulos).

Figure 2 . Macroscopic view of the tumor – cut surface . ( Courtesy Dr . V. Penopoulos ) .

Gastrografin swallow pass . The intragastric site of the drainage tube is evident . The protruding mass in the stomach ( green arrow ) represents the pancreatic remnant pancreato-gastric anastomosis (Courtesy Dr. V. Penopoulos)

Gross image of the gallbladder stricture. ( Courtesy Dr . V . Penopoulos ) (Courtesy Dr. V. Penopoulos).

ERCP image of gallbladder stricture. ( Courtesy Dr . V . Penopoulos ) (Courtesy Dr. V. Penopoulos).

MRCP showing probably a type II choledochal cyst. ( Courtesy Dr . V . Penopoulos ) (Courtesy Dr. V. Penopoulos).

Abdominal CT scan after 2 years. Red arrow - Small residual neoplasm. Green arrow - Small bowel loops (Courtesy Dr. V. Penopoulos)

a) Presence of numerous macrophages containing hemosiderin, cholesterol clefts, mixed with inflammatory cells and cellular debris. b) Presence of fibrocollagenous capsule and intraluminal necrosis (Courtesy Dr. V. Penopoulos)

a) Presence of numerous macrophages containing hemosiderin, cholesterol clefts, mixed with inflammatory cells and cellular debris. b) Presence of fibrocollagenous capsule and intraluminal necrosis (Courtesy Dr. V. Penopoulos)

Inferior hepatic vein after completion of the hepatectomy (Courtesy Dr. V. Penopoulos)

Surgical specimen of trisegmentectomy. Weight of resected liver: 578 g (Courtesy Dr. V. Penopoulos)

Undifferentiated sarcoma as the cause of the intussusception of the left hemicolon (Courtesy Dr. V. Penopoulos)

Presence of multiple metastases in the right lobe of the liver, 3 years after left hemicolectomy (Courtesy Dr. V. Penopoulos)

Specimen of trisegmentectomy of the right lobe of the liver (Courtesy Dr. V. Penopoulos)

Abdominal CT scan. Hemorrhagic rupture of a simple hepatic cyst without active hemorrhage. The presence of free intraperitoneal fluid is noted (Courtesy Dr. V. Penopoulos)

Inferior hepatic vein after completion of the hepatectomy (Courtesy Dr. V. Penopoulos)

Dissection and encircling of the superior and inferior hepatic veins (Courtesy Dr. V. Penopoulos)

Specimen of abdominoperineal resection for cancer of the anorectal junction (Courtesy Dr. V. Penopoulos)

Large metastatic hepatic lesion, involving segments V, VI, VII, and part of VIII, 4.5 years after abdominoperineal resection of the rectum for poorly differentiated adenocarcinoma (Courtesy Dr. V. Penopoulos)

Abdominal CT scan. Hemorrhagic rupture of a simple hepatic cyst without active hemorrhage. The presence of free intraperitoneal fluid is noted (Courtesy Dr. V. Penopoulos)

Operative field following excision of the huge pancreatic carcinoma (Courtesy Dr. V. Penopoulos)

Green arrow: gallstones. Blue arrow: blind orifice of the cystic duct (Courtesy Dr. V. Penopoulos)

Green arrow: gallstones. Blue arrow: blind orifice of the cystic duct (Courtesy Dr. V. Penopoulos)

Green arrow: gallstones. Blue arrow: blind orifice of the cystic duct (Courtesy Dr. V. Penopoulos)

Pathological findings. The maximum diameter of the tumor was 35 cm (Courtesy Dr. V. Penopoulos)

Pathological findings. The maximum diameter of the tumor was 35 cm (Courtesy Dr. V. Penopoulos)

Pathological findings. The maximum diameter of the tumor was 35 cm (Courtesy Dr. V. Penopoulos)

Pathological findings. The maximum diameter of the tumor was 35 cm (Courtesy Dr. V. Penopoulos)

Pathological findings. The maximum diameter of the tumor was 35 cm (Courtesy Dr. V. Penopoulos)

Sagittal opening of the specimen. Red arrows: gastric mucosa. Green arrows: Central pancreatic tumor necrosis (Courtesy Dr. V. Penopoulos)

Pancreatic carcinoma opened post operatively. The central necrosis is pointed by forceps (Courtesy Dr. V. Penopoulos)

Pathological findings. The maximum diameter of the tumor was 35 cm (Courtesy Dr. V. Penopoulos)

The area of gastric invasion by the expanding pancreatic carcinoma being the cause of intermittent bleeding (Courtesy Dr. V. Penopoulos)

En bloc excision of the pancreatic carcinoma together with the stomach and spleen (Courtesy Dr. V. Penopoulos)

Metastasis of primary pancreatic adenocarcinoma to a small pulmonary artery (Courtesy Dr. V. Penopoulos)

Green arrows — Cystic dilatation of intrahepatic biliary duct (Courtesy Dr. V. Penopoulos)

Percutaneous transhepatic cholangiography. Cystic dilatation of intrahepatic biliary duct with mucinous content (Courtesy Dr. V. Penopoulos)

Metastasis of primary pancreatic adenocarcinoma to a small pulmonary artery (Courtesy Dr. V. Penopoulos)
Liver
(0 images)No images in this chapter yet.
Biliary System
(0 images)No images in this chapter yet.
Pancreas
(0 images)No images in this chapter yet.
Spleen
(98 images)
Upper abdominal CT scan 1 year after splenic autotransplantation. Enhancement of the transplanted splenic tissue after contrast injection is evident, demonstrating its viability and function (Courtesy Dr. V. Penopoulos)

Splenic graft within the omental pouch, secured to the parietal peritoneum in the left subdiaphragmatic area (Courtesy Dr. V. Penopoulos)

Distal pancreatectomy-splenectomy specimen, with the ruptured splenic artery aneurysm visible (Courtesy Dr. V. Penopoulos)

Epithelial splenic cyst. The trabeculated internal surface is visible, which may exhibit various types of epithelial lining (Courtesy Dr. V. Penopoulos)

Epithelial splenic cyst. The trabeculated internal surface is visible, which may exhibit various types of epithelial lining (Courtesy Dr. V. Penopoulos)

Epithelial splenic cyst. The trabeculated internal surface is visible, which may exhibit various types of epithelial lining (Courtesy Dr. V. Penopoulos)

Epithelial splenic cyst. The trabeculated internal surface is visible, which may exhibit various types of epithelial lining (Courtesy Dr. V. Penopoulos)

Epithelial splenic cyst. The trabeculated internal surface is visible, which may exhibit various types of epithelial lining (Courtesy Dr. V. Penopoulos)

Surgical specimen of simple splenic cyst removal by partial splenectomy (Courtesy Dr. V. Penopoulos)

Macroscopic image of the splenectomy specimen. Littoral cell angioma (Courtesy Dr. V. Penopoulos)

Excision of a metastatic implant for histopathological examination (Courtesy Dr. V. Penopoulos)

Excision of a metastatic implant for histopathological examination (Courtesy Dr. V. Penopoulos)

Excision of a metastatic implant for histopathological examination (Courtesy Dr. V. Penopoulos)

Excision of a metastatic implant for histopathological examination (Courtesy Dr. V. Penopoulos)

Excision of a metastatic implant for histopathological examination (Courtesy Dr. V. Penopoulos)

Excision of a metastatic implant for histopathological examination (Courtesy Dr. V. Penopoulos)

Excision of a metastatic implant for histopathological examination (Courtesy Dr. V. Penopoulos)

a) Splenic white pulp, enlarged with the presence of a large number of neoplastic cells (small and round). b) Villous lymphocytes, characteristic of SMZL (Courtesy Dr. V. Penopoulos)

Splenectomy. Macroscopic image of the specimen. The dark red color of the splenic parenchyma is evident (Courtesy Dr. V. Penopoulos)

Green arrow – Splenic pedicle. Red arrow – Spleen fixed in retroperitoneal position. Courtesy Dr. V. Penopoulos.

Figure 2 . The cut surface of the spleen , showing multiple sponge-like vascular spaces . ( Courtesy Dr . V . Penopoulos ) .
Figure 4 .Anastomosing channels lined by tall and plump cells, showing micropapillary architecture in some regions, but without nuclear atypia or mitotic activity. Deposition of hemosiderin can be seen in some cells. ( Courtesy Dr . V . Penopoulos ) .

Figure 8 . The anastomosing channels lined cells express antigen FVIII. ( Courtesy Dr . V . Penopoulos ) .

Figure 3 . Large sinus-like anastomosing channels, with deciduous endothelial cells in the channel. ( Courtesy Dr . V . Penopoulos ) .

Figure 5 . The anastomosing channels lined cells express antigen CD31. (Courtesy Dr . V . Penopoulos ) .

Figure 6 . Endothelium of peripheral vessels express antigen CD34, but not the anastomosing channels lined cells. ( Courtesy Dr . V . Penopoulos ) .

Lower sections of abdominal computed tomography – Red arrow: Wandering spleen torsion. Courtesy Dr. V. Penopoulos.

Red arrow – Wandering spleen. Pink arrow – Gastric volvulus. Brown arrow – Liver. Courtesy Dr. V. Penopoulos.

Green arrow – Splenic pedicle. Red arrow – Spleen fixed in retroperitoneal position. Courtesy Dr. V. Penopoulos.

Green arrow – Splenic pedicle. Red arrow – Spleen fixed in retroperitoneal position. Courtesy Dr. V. Penopoulos.

The enlarged spleen in cross-section – dark-colored, soft and elastic consistency, measuring 21 x 13 x 9 cm. Courtesy Dr. V. Penopoulos.

Endoscopic image after performance of splenectomy. Complete disappearance of the varices of the fundus of the stomach (Courtesy Dr. V. Penopoulos)

Abdominal CT scan. Visible presence of varices at the hilum of the spleen (Courtesy Dr. V. Penopoulos)

Endoscopic image after performance of splenectomy. Complete disappearance of the varices of the fundus of the stomach (Courtesy Dr. V. Penopoulos)

Endoscopic image after performance of splenectomy. Complete disappearance of the varices of the fundus of the stomach (Courtesy Dr. V. Penopoulos)

Endoscopic image after performance of splenectomy. Complete disappearance of the varices of the fundus of the stomach (Courtesy Dr. V. Penopoulos)